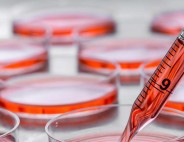

Bringing Work to Life
23 Mar, 2016
Life Sciences and Biotech Gain Momentum
By Mark Kleszczewski
While not immune to lingering fallout from the 2008-09 economic crisis, the bioscience industry has weathered difficult times better than most industries and is on course to regain its previous high employment levels, according to the Biotechnology Innovation Association (BIO) and research-and-development (R&D) leader Battelle. Indeed, despite drug pricing controversies and lost income from expiring patents, the promise of bioscience-based solutions to global problems in human health, food security, sustainable industrial production and environmental protection provides an optimistic picture for the biosciences as a key economic development engine in North America.
According to BIO/Battelle’s most recent in-depth analysis, economic output of the bioscience industry has expanded significantly with 17 percent growth since 2007, nearly twice the national private sector nominal output growth. The research, testing and medical laboratories subsector has been the primary driver of bioscience industry job growth—increasing employment by 28 percent since 2001 and by nearly 10 percent since 2007.
Industry Continues Rebound
According to analysts at EY, the dynamics that made 2015 a record year for U.S. deal-making will continue into 2016, pointing to ongoing resilience in mergers-and-acquisitions (M&A) activity. The appetite for deals in life sciences was exceptionally strong in 2015, with values soaring 44.7 percent to a record-high $462.2 billion compared to $319.5 billion in 2014.
“Pharmaceutical companies are being rewarded for narrowing their strategic focus to fewer businesses and therapeutic areas,” said Jeff Greene, global life sciences leader, transaction advisory services, EY, in a recent company report. “Several factors will likely have a positive impact on future M&A activity including: a more restricted IPO window for biotech companies; continued pricing pressure, which will spur more consolidation across the industry; the growth imperative; the need for increased scale, along with firepower; and a continuing trend of shareholder activism.”
He noted that disruption is also expected to lead to more M&A activity driven by changes in consumer behavior and access to new technologies. “Partnerships with technology companies in the consumer health and innovative therapy segments will continue,” said Greene. “Additionally, there is an increased push to securely create, collect, curate and manage patient data. Whether this takes the form of connected wearable devices or at-home monitoring, today’s partnerships will likely drive deals in the medium to long term. We could also see more collaboration between large and small biopharma players, with immuno-oncology being a key focus.”
Regaining Momentum and Growth
With most company valuations remaining high, long-time industry clusters—like the pharmaceuticals hub concentrated in Massachusetts—are still going strong and even growing. In 2013, Johnson & Johnson launched an innovation center in Boston, followed by Pfizer opening a research hub in Cambridge in 2014.
Last year, GE moved its $4 billion life sciences and healthcare headquarters to a former Hewlett Packard campus in Marlborough, where it will share a building with Quest Diagnostics. When fully operational in 2017, GE’s facility will house 500 employees. Company officials have stated that they chose Marlborough for the new headquarters because of its experience in the region, proximity to Boston and a ready pool of other life sciences companies.
The move follows those made by Irish Shire plc, to shift 500 jobs to its Lexington campus, and Illinois-based Baxter International, which is developing its new biopharmaceutical research center in Cambridge, and the announcement by Bristol-Myers Squibb Co. to open a drug-discovery center focusing on genetic diseases in Kendall Square in 2018.
Another thriving industry ecosystem ramping up activity and emphasizing cross-sector collaborations can be found in the communities of Mississauga and Brampton, both within the Greater Toronto Area of Ontario, Canada.

Baylis Medical’s Expansion and new second facility Opening in Mississauga. From Left: Mayor Bonnie Crombie, Mississauga, Kris Shah Presidents of Baylis Medical and Laura Conquergood, Director of Operations at Baylis Medical. Photo by Baylis Medical
It’s a pivotal location for distribution with logistical and transportation requirements, while also being home to a diverse, creative class of scientists, experts and engineers that builds technologies and innovations used globally, says Susan Amring, director of economic development at the City of Mississauga (Ontario) Economic Development Office.
“We’re already known as ‘Pill Hill’ for the number of companies that have located here in Mississauga, but we’re not just busy in pharma,” she adds. “We’ve had several new announcements in 2015, particularly in biopharmaceuticals, oncology, neurology, medical devices, supplies, diagnostics and IT healthcare coming from companies like Meda Pharmaceuticals, Aplab, Davis Medical, Alphora, TheraPure and Novadaq Technologies which are continuing to grow. Also, Roche has been growing by leaps and bounds, bringing in many new employees for research and development, and clinical trial work.”
Amring says that convergence between Mississauga’s life sciences and information and communications technology cluster is particularly promising, making the city a leader in advancing innovation and delivery of emerging digital health solutions.
“To further leverage current opportunities and support future sector growth here, we have a research innovation commercialization center located in Mississauga that we partner with and have hired a sector specialist to work with the life sciences community directly,” continues Amring.
One of the keys to Mississauga’s success, Amring says, stems from having a life sciences talent base that has grown 25 percent in the past 10 years. “We’ve got partnerships with BioTalent and Life Sciences Ontario, great relationships with 12 teaching hospitals and highly-regarded, post-secondary institutions, including the University of Toronto-Mississauga, which has developed a Masters of Biotechnology and other programs to support the local life sciences sector,” notes Amring.
Area assets include Toronto’s Pearson International airport and a strong transportation infrastructure of transcontinental highways and CN, the largest intermodal railway terminal in Canada.
Being at the center of the country’s major transportation corridors, while also offering close proximity to the U.S. border and 158 million consumers, makes neighboring Brampton an ideal place to locate North American operations, explains Sohail Saeed, director of economic development and tourism at the City of Brampton (Ontario) Economic Development Office.
Especially in the past decade, Ontario became the hub for advanced manufacturing and a lot of R&D, with the biopharmaceutical sector among the province’s most research-intensive industries, investing more than $1 billion in R&D and employing more than 16,500 workers, says Saeed. The province also has more than 900 medical device companies, making it the second-largest med/tech cluster of its kind in North America.
Saeed notes that a rich community of researchers, suppliers and healthcare practitioners has made Brampton—Canada’s ninth-largest and second-fastest growing city—especially attractive to world-renowned companies like device maker Medtronic, Taro Pharmaceuticals—which has invested millions at its Brampton site in the past two years, and Canada Blood Supply, whose $11 million expansion has made it one of the busiest blood supply centers in Canada.
“We are also one of the very few cities left in the Toronto suburban area with land available for further development,” says Saeed. “That’s a great opportunity for companies and institutions which are poised for growth, like Brampton Civic Hospital, Peel Memorial Integrated Wellness Center and ErinoakKids—the largest children’s treatment center in Ontario.
Back in the United States, an extensive number of major life science firms have chosen to build headquarters in the life sciences cluster centered around Madison, Wisconsin, and surrounding Dane County, a long-standing leader in world-class biotech R&D, says Paul Jadin, president at the Madison (Wis.) Region Economic Partnership.
“There’s no question that biotech and life sciences are among our top applied sectors, they are growing exponentially here and are attractive for industry companies seeking research partners, joint ventures, and transfer and production capabilities,” he says.
The Madison region’s life sciences sector is driven largely by UW-Madison, which ranks fourth nationwide in federal research funds with more than $1 billion in expenditures, more than half of which is spent directly in life sciences. Higher education institutions in and adjacent to the region propagate an infusion of young talent into the life sciences industry, with 9,000 sector-related degree conferrals in 2014, including UW-Madison’s Master’s degree in bioscience.
The region’s employment in scientific R&D services grew by nearly 150 percent between 2005 and 2010, and the bioscience industry directly supported more than 10,000 regional jobs in 2014, says Jadin. Employment is balanced between large, nationally known companies such as Promega, Covance, Thermo Fisher Scientific and GE Healthcare, and smaller ones such as Stemina, Lucigen, and Quintessence Biosciences. Companies like Exact Sciences, Cellular Dynamics, SHINE Medical Technologies and Northstar Medical Radioisotopes have successfully transferred products from research to market, choosing to remain in the Madison region to build manufacturing facilities and create related jobs.
The Madison region fosters life science entrepreneurs through its many incubation and research spaces, such as University Research Park, Wisconsin Institute for Discovery and Morgridge Institute for Research. Supporting institutions such as BioForward, Wisconsin Alumni Research Foundation and the Clinical Trials Education Network of WI also provide resources to help bioscience researchers and companies move from the lab to the marketplace.
As innovations continue to be borne out of the bioscience expertise in the region, opportunities for resulting technologies to fuel new, advanced manufacturing opportunities will be a significant regional asset, adds Jadin. He says that well-funded R&D initiatives, competitive higher-education institutions injecting young talent into the life sciences workforce and established support institutions will continue to solidify the Madison region’s role as a leader in the life sciences.
Building industry talent from a very early age, while tending to today’s business needs, is a priority in Flagler County, Florida, a high-tech corridor ranked fourth-largest ‘hot spot’ for tech jobs in the U.S.
“Flagler County’s future economy depends on how well we prepare our youngest generation for success after high school, whether that’s college, career training or the workplace,” says Helga van Eckert, executive director at the Flagler County (Fla.) Department of Economic Opportunity.
The area offers access to 21 hospitals providing neo-natal facilities and care and plays host to award-winning Florida Hospital Flagler, a member of Adventist Health Systems. In 2015, the hospital helped launch the Rymfire Elementary Flagship medical lab, “Locos Medica,” by donating nearly $7,000 worth of medical equipment to help K-6 students connect what they learn in the classroom and medical lab to future careers in the industry.
All are part of a local cluster that includes companies like Whitney Labs, Beutlich Pharmaceutical, Florida Suncare and Testing, and Designs for Health—a provider of high-quality nutritional supplements to healthcare professionals. The company is investing $3 million in site acquisition and upgrades and creating an additional 50 jobs in Flagler County over the next five years.
“It’s important that we expand in an area that can accommodate our projected growth, provide a qualified workforce pipeline and meet our financial criteria,” states company president Phil Lizotte. “Flagler County remains a great fit. We look forward to continuing our partnership.”
Moving over to the mid-Atlantic region, Maryland is a leading location of bioscience and biotechnology growth tied to innovations from government and academia.
“We’re seeing continued strength in life sciences and healthcare in our region, and a strong increase in the development and manufacturing of medical devices here. There’s a lot of activity in new med tech and patents that involve plastics, elastomers and polymers, due to the very strong R&D component at our facilities,” says Lisa Webb, director at the Cecil County (Md.), Office of Economic Development.
“A lot of what makes Cecil County unique in this sector are special assets like the U.S. Army Edgewood Chemical Biological Center at Aberdeen Proving Ground, specialized support from the University of Delaware and the link to our local college, which just created a four-year program in materials science,” she says.
There’s also the overall environment favorable for siting physical production, Webb continues. “Our industrial base is very diverse, and manufacturing is predominantly high in our region because we have good incentives and the infrastructure that manufacturers need: good wage rates and plentiful water, land and power.”
In terms of human capital, Webb says that not only is there a workforce appropriate for the industry, there is also funding available to help train workers on specific equipment if necessary.
Other advantages Webb points to are the county’s strategic location in the northeastern part of the state between Baltimore and Philadelphia which provides convenient access to major international airports, the Interstate 95/U.S. 40 corridor and the Port of Baltimore.
Additional assets that have positioned the region for the next phase of growth in the sector are nine business parks on highly desirable land within enterprise zones and access to cross-industry initiatives like the Regional Additive Manufacturing Partnership of Maryland, formed in conjunction with Hartford County.
Webb says that notable industry employers growing in the region range from startups like specialty filtration device maker Micropore to multinational manufacturer W.L. Gore—which employs about 2,400 people at 13 local production facilities. Also in growth mode are Japanese-owned Terumo Medical and Terumo Cardiovascular, which are launching three new production lines and expected to expand their headcount to nearly 200 total people.
In addition, the nearby 40-acre Delaware Technology Park acts as a highly focused science research hub featuring the world-class Delaware Biotechnology Institute and the Fraunhofer Center for Molecular Biotechnology. Both are positioned to be leaders in human health research in such areas as Alzheimer’s and other diseases.
Mark Kleszczewski is president and CEO of GoBusiness Group, LLC and a freelance writer on critical business topics. He can be reached at mark@gobusinessgroup.net
For more details on the organizations featured in this article, visit:
Cecil County (Md.) Office of Economic Development cecilbusiness.org
City of Mississauga (Ontario) Economic Development Office winthehumanrace.ca
City of Brampton (Ontario) Economic Development Office brampton.ca
Flagler County (Fla.) Dept. of Economic Opportunity flaglercountyedc.com
Madison (Wis.) Region Economic Partnership (MadREP) madisonregion.org
Related Posts
-
Public-Private Collaboration Aims to Find a New Treatment for Pancreatic Cancer
-
The Bioscience Bioeconomy Bonanza
-
Southeast Biotech Campus Fuels Entrepreneurs and Growing Ventures Labs for Lease in Increments Startups Can Afford in a Community of Biotechs
-
Biotech and Pharmaceutical Industry
-
Embraced by More States as an Economic Engine
-
Considering Data Demand
-
Breathing Life Back Into Bioscience
-
Bioscience’s Bright Spots
-
What’s in Store for Biopharma?